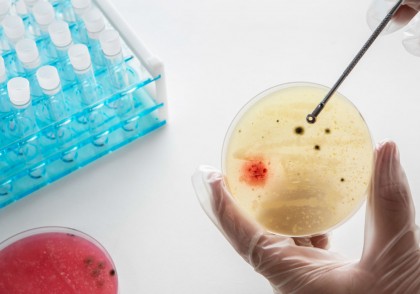
Terapia bacterienă împotriva cancerului

Terapia bacterienă împotriva cancerului
Descoperirea ar putea îmbunătăți siguranța și eficacitatea tratamentelor oncologice bazate pe bacterii
Context și importanța descoperirii
De la sfârșitul anilor 1800, cercetătorii au explorat utilizarea bacteriilor antitumorale ca o strategie inovatoare pentru tratarea cancerului. Cu toate acestea, aplicarea clinică a acestor terapii a fost limitată din cauza problemelor de siguranță și eficacitate.
Un nou studiu realizat de o echipă de cercetători de la Shenzhen Institutes of Advanced Technology și Shanghai Institute of Nutrition and Health, ambele din cadrul Academiei Chineze de Științe, a dezvăluit mecanismul prin care bacteriile modificate genetic pot stimula răspunsul imunitar împotriva tumorilor.
Publicat în revista Cell, studiul a demonstrat modul în care o tulpină bacteriană modificată, denumită Designer Bacteria 1 (DB1), poate supraviețui și prolifera exclusiv în țesutul tumoral, având un dublu efect de țintire și eliminare a tumorilor.
Cum funcționează terapia cu bacterii modificate genetic?
- DB1 se acumulează selectiv în tumori, evitând sistemul imunitar al gazdei în țesuturile sănătoase.
- Activează un tip special de celule imunitare, cunoscute sub numele de celule T CD8+ de memorie rezidente în țesut (TRM), care sunt esențiale pentru distrugerea celulelor tumorale.
- Interleukina-10 (IL-10), o moleculă critică din microambientul tumoral, este utilizată pentru a regla activitatea acestor celule imune.
- DB1 stimulează expresia receptorului IL-10R pe celulele CD8+ TRM, consolidând un ciclu de activare care îmbunătățește imunitatea antitumorală.
Descoperirea unui mecanism-cheie: efectul de memorie al receptorului IL-10R
O descoperire majoră a acestui studiu este histereza receptorului IL-10R. Cercetătorii au identificat o buclă de feedback pozitiv, în care IL-10 se leagă de IL-10R, activând STAT3, o proteină care stimulează producția suplimentară de IL-10R. Acest efect creează o memorie celulară, permițând celulelor T să rețină stimularea anterioară cu IL-10 și să fie mai eficiente în combaterea tumorilor.
Impactul IL-10 asupra microambientului tumoral
După terapia cu DB1, macrofagele asociate tumorii (TAMs) cresc producția de IL-10 prin activarea caii de semnalizare Toll-like receptor 4 (TLR4). Acest lucru are două efecte esențiale:
- Reduce viteza de migrare a neutrofilelor asociate tumorii (TANs), ceea ce împiedică eliminarea rapidă a bacteriilor DB1 de către sistemul imunitar.
- Permite bacteriilor DB1 să persiste mai mult în tumoră, crescând astfel eficacitatea lor terapeutică.
Concluzii și implicații pentru viitor
Această descoperire elucidează un mecanism esențial pentru îmbunătățirea siguranței și eficacității terapiei bacteriene împotriva cancerului.
Profesorul Liu Chenli, unul dintre autorii principali ai studiului, afirmă:
"Mecanismul de histereza IL-10R nu doar că oferă informații valoroase despre interacțiunile dintre bacterii și sistemul imunitar, dar poate servi și ca principiu ghid pentru proiectarea unor bacterii modificate genetic mai eficiente în lupta împotriva cancerului."
Această inovație ar putea deschide calea spre terapii oncologice personalizate, bazate pe bacterii modificate genetic, care să stimuleze imunitatea naturală a pacienților împotriva tumorilor.
Bacterial immunotherapy leveraging IL-10R hysteresis for both phagocytosis evasion and tumor immunity revitalization.
Cell.
doi.org/10.1016/j.cell.2025.02.002
Image by freepik
Copyright ROmedic: Articolul se află sub protecția drepturilor de autor. Reproducerea, chiar și parțială, este interzisă!
- Semne și simptome de alertă pentru pacienții cu cancer colorectal cu debut precoce
- Incidența cancerului de col în rândul femeilor tinere, în creștere în ultimii 10 ani
- Insecuritatea alimentară este asociată cu un risc crescut de deces în rândul supraviețuitorilor de cancer
- O moleculă produsă în urma dietelor cetogene poate preveni cancerul colorectal
- Implant silicon sani
- Pentru cei cu anxietate si atacuri de panica FOARTE IMPORTANT
- GRUP SUPORT PENTRU TOC 2014
- Histerectomie totala cu anexectomie bilaterala
- Grup de suport pentru TOC-CAP 15
- Roaccutane - pro sau contra
- Care este starea dupa operatie de tiroida?
- Helicobacter pylori
- Medicamente antidepresive?
- Capsula de slabit - mit, realitate sau experiente pe oameni